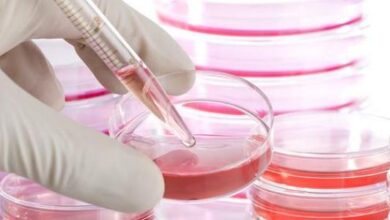

محتويات

يمثل النزيف الطبيعي نزول دم الدورة الشهرية لمدة تبلغ حوالي خمسة أيام كل 21-35 يوماً، في حين أنّ النزيف الرحمي غير الطبيعي يتمثل بنزول الدم خلال الفترة ما بين دورتين شهريتين متتاليتين، أو النزيف لفترات طويلة، أو تدفق غزير للدم.[١]
يحدث النزيف الرحمي غير الطبيعي بشكلٍ رئيسي بسبب حدوث خللٍ في توازن الهرمونات الجنسية في جسم المرأة، ويُعزى حدوث هذه الحالة إلى مجموعة من العوامل والأسباب، ومن هذه الأسباب ما يأتي:[٢]
- البلوغ أو الوصول إلى سنّ اليأس: إذ إنّ هذه المراحل يُرافقها عدم اتّزان في مستوى الهرمونات لأشهر أو سنوات، إذ يظهر الدم في هذه الحالة باللون البنيّ، أو الوردي، أو الأحمر الفاتح، وقد يكون نزول الدم إمّا متقطعاً، أو غزيراً، أو على هيئة بقع، والذي يتمثل بنزول دم أخف من فترة الدورة الشهرية الطبيعية.
- متلازمة تكيّس المبيض: (بالإنجليزية: Polycystic ovary syndrome)، تُعتبر هذه المتلازمة إحدى اضطرابات الغدد الصمّاء، إذ تُسبب زيادة في مستوى الهرمونات الجنسية في جسم المرأة، بالإضافة إلى حدوث خللٍ في مستوى هرموني الإستروجين (بالإنجليزية: Estrogen) والبروجستيرون، وتؤدي إلى عدم انتظام الدورة الشهرية (بالإنجليزية: Irregular periods).
- الانتباذ البطاني الرحمي: (بالإنجليزية: Endometriosis)، يسبّب الانتباذ البطاني الرحمي غزارة الطمث خلال فترة الدورة الشهرية المنتظمة، إذ تحدث هذه الحالة عند نمو بطانة الرحم خارجه مثل المبيضين.
- سلائل الرحم: (بالإنجليزية: Uterine polyps)، يُعدّ سبب سلائل الرحم غير معروف، حيث تُعاني المرأة في هذه الحالة من نمو زوائد صغيرة داخل الرحم، ويؤثر مستوى هرمون الإستروجين في نمو هذه الزوائد، وتجدر الإشارة إلى أنّ الأوعية الدموية صغيرة الحجم الموجودة في هذه السلائل اللحمية قد تكون سبباً في حدوث النزيف الرحمي غير الطبيعي، بما في ذلك ظهور البقع خلال الفترة الواقعة بين الدورات الشهرية.
- الورم الليفي في الرحم: (بالإنجليزية: Uterine fibroids)، يُذكر بأنّ السبب الدقيق لحدوث تليّف الرحم غير معروف، حيث يظهر الورم الليفي الرحمي على هيئة نمو زوائد صغيرة داخل الرحم، أو بطانة الرحم، أو عضلة الرحم، ويُعتقد بأنّ هرمون الإستروجين يلعب دوراً في نمو هذه الأورام الليفية.
- الإصابة بالأمراض المنقولة جنسيّاً: تؤدي الإصابة بهذه الأمراض مثل مرض السيلان (بالإنجليزية: Gonorrhea) أو الكلاميديا (بالإنجليزية: Chlamydia) إلى حدوث التهابات، وبالتالي حدوث النزيف الرحمي غير الطبيعي.
- الأدوية: قد يكون تناول أدوية مُعينة مسؤولاً عن حدوث النزيف الرحمي غير الطبيعي، ومن الأمثلة على هذه الأدوية حبوب منع الحمل، أو العوامل الهرمونية، أو الوارفارين (بالإنجليزية: Warfarin).
لتشخيص الإصابة بهذه الحالة قد يطلب الطبيب من المرأة تسجيل الملاحظات المُتعلّقة بالدورة الشهرية الخاصة بها، إذ يساعد ذلك على إعطاء معلومات حول الأعراض التي تُعاني منها المرأة، ويُجري الطبيب أيضاً الفحص البدني، كما يوجّه بعض الأسئلة المُتعلّقة بالصحّة العامّة للمرأة، وقد يطلب إجراء فحص الحمل أيضاً، إضافة إلى ما سبق قد تُجرى فحوصات أخرى، ويُمكن إجمال أهمّها فيما يأتي:[٣]
- فحص الدّم: يمكن الكشف عن مستوى الحديد في الجسم من خلال فحص الدم، إذ إنّ النّزيف الغزير يسبب نقص الحديد، كما يُمكّن فحص الدّم من الكشف عن مستوى الهرمونات، بالإضافة إلى الكشف عن الإصابة باضطربات الدّم أو الأمراض المُزمنة.
- الفحص بالموجات فوق الصوتية: يُمكّن هذا الفحص من الكشف عن الأورام الليفية أو سلائل الرحم، حيث إنّه يُعطي صورة عمّا في داخل الرحم.
- التنظير الرّحمي: (بالإنجليزية: Hysteroscopy)، يُدخل الطبيب منظاراً صغيراً مُضاءً في عنق الرحم، حتى يتمكن من رؤية ما في داخل الرحم.
- الخزعة: يأخذ الطبيب عينة صغيرة من الأنسجة لفحصها تحت المجهر للكشف عن وجود خلايا غير طبيعية.
- التصوير بالرنين المغناطيسي: (بالإنجليزية: Magnetic Resonance Imaging) واختصاراً (MRI)، يُلجأ إلى هذه التّقنية بهدف تقديم صُوَر مفصلة للرحم، وتجدر الإشارة إلى أنّ هذه التّقنية تستخدم في حالات مُعينة مثل الكشف عن موضع العضال الغدي (بالإنجليزية: Adenomyosis).
تتوفر العديد من الطرق العلاجية لعلاج النّزيف الرحمي، وفيما يأتي بيان لكلٍ منها:[٤]
- العلاجات الدوائية: من العلاجات الدوائية المستخدمة ما يأتي:
- حبوب منع الحمل: (بالإنجليزية: Oral Contraceptives)، تمنع هذه الأدوية من نمو وتطور بطانة الرحم، وتُمكّن من إعادة النزيف الرحمي المتوقع إلى وضعه الطبيعي، وتقليل تدفق الطمث، والتقليل من خطر الإصابة بفقر الدم الناجم عن نقص الحديد.
- الإستروجين: يُحفز الإستروجين عودة نمو بطانة الرحم إلى وضعه الطبيعي بسرعة.
- بروجيستين: (بالإنجليزية: Progestin)، قد يُعطى هذا الدواء إمّا على فترات مُعينة أو بشكلٍ مستمر، لعلاج الحالات المزمنة من النّزيف الرحمي غير الطبيعي.
- ديسموبريسين: (بالإنجليزية: Desmopressin)، يُعدّ هذا الدواء الخيار أخير لعلاج نزيف الرحم غير الطبيعي لدى المرضى الذين يعانون من اضطرابات تجلط الدم (بالأنجليزية: Coagulation disorders).
- استئصال الرحم: (بالإنجليزية: Hysterectomy)، تُجرى عملية استئصال الرحم من خلال البطن أو المهبل في العديد من الحالات، منها رفض العلاج الهرموني أو فشله، أو المعاناة من أعراض فقر الدم، أو االمعاناة من اضطراب في الحياة نتيجة النزيف المُستمر أو غير المُتوقع.
- استئصال بطانة الرحم: (بالإنجليزية: Endometrial ablation)، يُعتبر هذا الحل بديلاً للنّساء اللاتي لا يرغبن بالخضوع إلى عملية استئصال الرحم، أو اللاتي لا يمكنهنّ الخضوع إلى عملية جراحية كُبرى.
شاهد هذا الفيديو لتعرف ما هو النزيف الرحمي:
- ↑ “Uterine Bleeding: Abnormal Uterine Bleeding”, www.my.clevelandclinic.org, Retrieved 8-7-2018. Edited.
- ↑ “What Causes Dysfunctional Uterine Bleeding?”, www.healthline.com, Retrieved 8-7-2018. Edited.
- ↑ “What Is Abnormal Uterine Bleeding?”, www.webmd.com, Retrieved 8-7-2018. Edited.
- ↑ “Abnormal (Dysfunctional) Uterine Bleeding”, www.emedicine.medscape.com, Retrieved 8-7-2018. Edited.